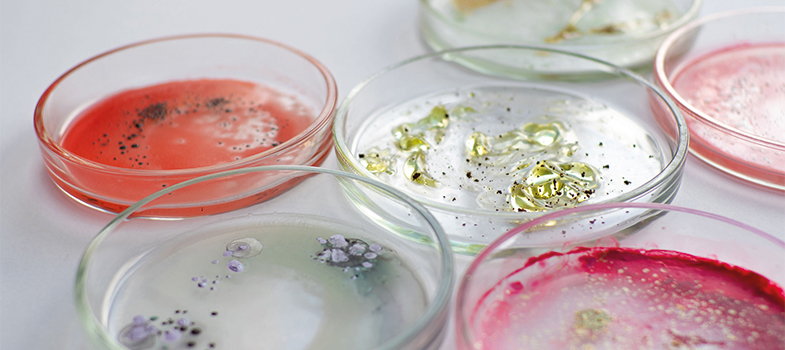
Isolating and identifying bacteria (human health) (2025)

Already Registered?
If you create an account, you can set up a personal learning profile on the site.
For further information, take a look at our frequently asked questions which may give you the support you need.
If you have any concerns about anything on this site please get in contact with us here.